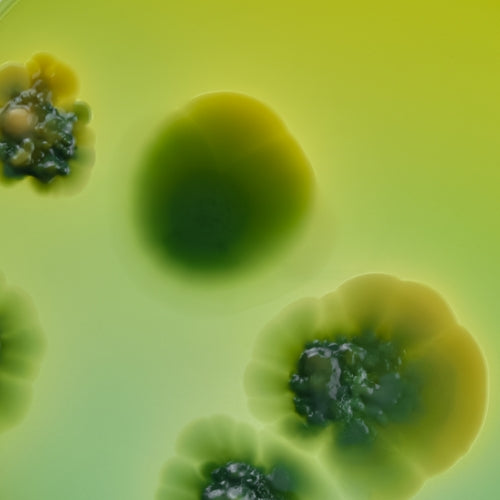

Derniers articles Derniers articles
-

Comment bien prendre ses compléments alimentaires
Sarah AmmerahlComment bien prendre ses compléments alimentaires
Sarah AmmerahlÉquipe R&D, Biologiste -

SIBO – quand l’intestin grêle est mal colonisé
Par Helga WiesmannSIBO – quand l’intestin grêle est mal colonisé
Par Helga WiesmannAuteur pour la santé, Naturopathe -

5 conseils pour se rétablir rapidement après de...
Sarah Ammerahl5 conseils pour se rétablir rapidement après des antibiotiques
Sarah AmmerahlÉquipe R&D, Biologiste -

Bactéries intestinales : une aide pour le systè...
Sarah AmmerahlBactéries intestinales : une aide pour le système immunitaire?
Sarah AmmerahlÉquipe R&D, Biologiste
1
/
de
4
Tous les articles
Restez informé
Offres exclusives, lancements de produits et dernières nouvelles scientifiques sur le microbiote intestinal dans votre boîte mail.
J'accepte de recevoir les emails de Nupure.